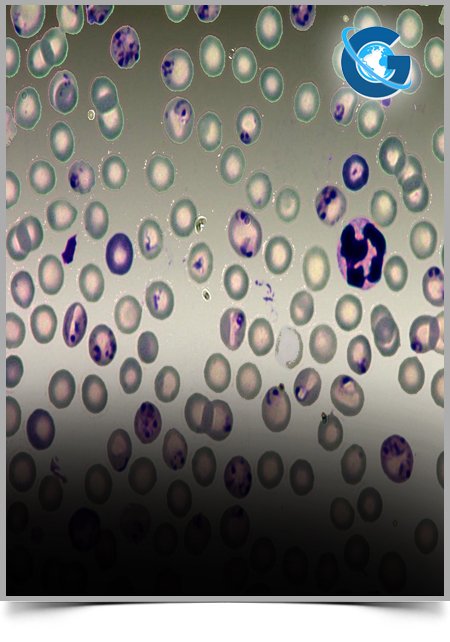
Evaluation of Antibacterial Activity of Nano silver Particles on Clinical Isolates of Acinetobacter baumannii

International Journal of Bacteriology & Parasitology
ISSN: 2688-6391
Impact Factor: 1.3
Evaluation of Antibacterial Activity of Nano silver Particles on Clinical Isolates of Acinetobacter baumannii
Seyedeh Nasim Karimipour, Asghar Tanomand, Hasan Hosainzadegan*, Amir Hasan Zadeh
International Journal of Bacteriology & Parasitology
Biomathematical Analysis of the Liver Fibrosis
Bin Zhao*, Deng Lebin, Yuan Li, Gao Guosheng
International Journal of Bacteriology & Parasitology
High Frequency of Beta-Lactam Resistance Among Staphylococcus au- reus Isolated from Bovine Mastitis in Northeast of Brazil
André S. Santos*, Débora C. V. Lima, Atzel C. A. Abad, José G. Silva, Júnior M. B. Oliveira, Pollyanne R. F. Oliveira, Vin/ycius S. Amorim, Mateus M. Costa, Rinaldo A. Mota
International Journal of Bacteriology & Parasitology
Mitogen-activated Protein Kinase p38, not ERK1/2 and JNK, Regulates Nitric Oxide Response to Salmonella Heidelberg Infection in Chicken Macrophage HD11 Cells
Haiqi He*, Kenneth J. Genovese, Christina L. Swaggerty, David J. Nisbet, Michael H. Kogut
International Journal of Bacteriology & Parasitology
Serotype Distribution and Antimicrobial Susceptibility Profile of Streptococcus pneumoniae Among Myanmar Children with Acute Respiratory Infection
Thi Thi Htoon*, Nan Aye Thida Oo, Wah Wah Aung, Hlaing Myat Thu, Mon Mon, Masaya Yamaguchi, Shigetada Kawabata, Kyaw Zin Thant
International Journal of Bacteriology & Parasitology



